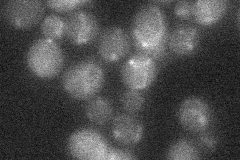
YLR213C
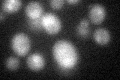
YLR213C
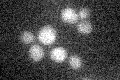
YLR213C

View description
Putative glycoside hydrolase of the spore wall envelope; required for normal spore wall assembly, possibly for cross-linking between the glucan and chitosan layers; expressed during sporulation
Localization:
Intensity:
Fold change:
Significance:
-
C’ GFP library in SD

below threshold15.68 -
N' NOP1pr-GFP in SD

vacuole48.5262 -
N' TEF2pr-mCherry in SD

vacuole27.8095 -
N' NATIVEpr-GFP in SD
below threshold16.2907 -
N' TEF2pr-VC and Cyto-VN in SD

#N/A0 -
C’ GFP library in SD+DTT
cytosol16.771.06No -
C’ GFP library in SD+H2O2

cytosol16.251.03No -
C’ GFP library in Starvation Media
cytosol17.91.14No -
C’ GFP library on the background of Pup2-DaMP

below threshold -
C’ GFP library on the background of CCT mutant

below threshold16.00431.02024No
